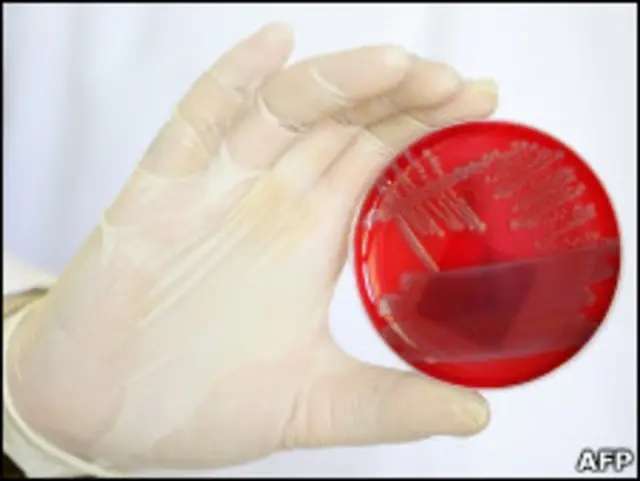
Cientista mostra cultivo de colônia de bactérias E.coli responsáveis por surto de infecções na Alemanha

Bactéria causadora de surto de infecções intestinais é desconhecida, diz OMS
Crédito, AFP
O surto de infecções intestinais iniciado na última semana na Alemanha é provocado por um subtipo até então desconhecido da bactéria E.coli, segundo afirmou nesta quinta-feira a OMS (Organização Mundial da Saúde).
A infecção pela bactéria pode provocar forte diarreia e vômito e levar a problemas nos rins.
Mais de 1.500 pessoas já desenvolveram graves infecções gastrointestinais provocadas pela bactéria, e 17 pessoas morreram – 16 na Alemanha e uma na Suécia.
“Essa cepa (variação da bactéria) nunca tinha sido vista antes em uma situação de epidemia”, afirmou a porta-voz da OMS Aphaluck Bhatiasevi.
Pesquisadores da Alemanha também afirmaram que análises genéticas preliminares sobre o surto mostram que a bactéria responsável pelas infecções é desconhecida.
Segundo eles, a bactéria tem genes de dois grupos distintos de E.coli: a E.coli enteroagregativa (EAEC) e a E.coli enterohemorrágica (EHEC).
Cientistas do Instituto de Genômica de Pequim, na China, que estudaram a bactéria afirmaram que ela é uma nova cepa “altamente infecciosa e tóxica”.
Pepino
As autoridades alemãs haviam inicialmente responsabilizado pepinos importados da Espanha como foco, mas depois descartaram a possibilidade e dizem que ainda tentam descobrir a origem da contaminação.
O chefe do instituto de saúde pública que lidera o combate ao surto de E.coli na Alemanha afirmou à BBC que pode levar meses para que a epidemia seja contida.
Segundo Reinhard Burger, presidente do Instituto Robert Koch, é possível que nunca se descubra a fonte das infecções.
Pelo menos 365 novos casos de infecção pela E.coli foram registrados somente na quarta-feira. Em um quarto dos casos, os pacientes desenvolveram síndrome hemolítico-urêmica, que leva a problemas nos rins e pode matar.
Além da Alemanha, outros oito países europeus já registraram casos de infecção pela E.coli – Áustria, Dinamarca, Holanda, Noruega, Espanha, Suécia, Suíça e Grã-Bretanha.
Também foram identificados dois casos nos Estados Unidos, de pacientes que haviam recentemente viajado a Hamburgo, onde se concentra boa parte dos casos.
Virtualmente todas as pessoas infectadas ou vivem na Alemanha ou haviam viajado recentemente ao país.
Vários países tomaram medidas para tentar se prevenir do surto, como a proibição da importação de pepinos e a remoção de legumes e verduras das prateleiras dos mercados.
























